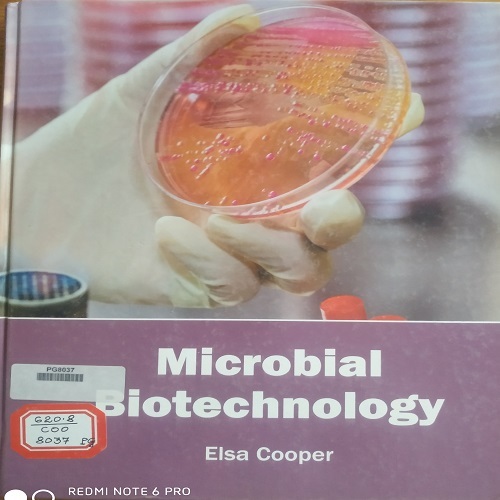

About Deogiri College Library
Deogiri College, Aurangabad is run by the Marathwada Shikshan Prasarak Mandal’s Aurangabad. It is affiliated to Dr. Babasaheb Ambedkar Marathwada University, Aurangabad. It is one of the foremost colleges in Marathwada Region. It is established in the year 1960.
Read more